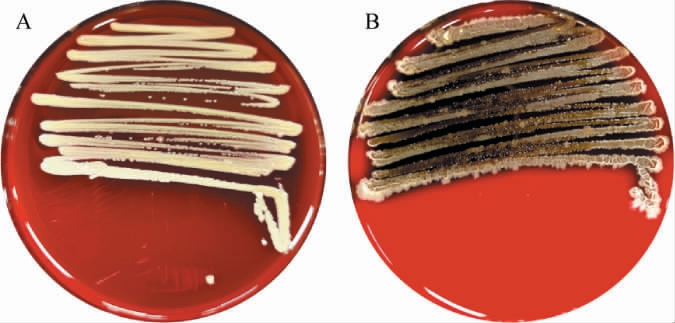

单萜类化合物是一类由两个异戊二烯单元(即10个碳原子)缩合而成的萜类化合物,具有较强的挥发性和浓郁的香气,广泛存在于各种植物精油中,如薄荷油、橘子油、牡丹油、松节油等[1-2]。由于其丰富的药理学和生物学活性,已经被广泛应用于各个领域,芳樟醇因其显著的抗菌和抗氧化活性,常被用作食品防腐剂,以延长食品的保质期[3]。香芹类化合物(香芹酮、香芹醇、二氢香芹酮、二氢香芹醇)可通过抑制γ-氨基丁酸A型受体(γ-aminobutyric acid type A receptor,GABAA)或调节乙酰胆碱酯酶活性等机制发挥杀虫作用[4]。此外,α-松油醇具有镇痛、胃黏膜保护、心脏保护、神经保护、止泻以及促皮渗透等作用[3],而桉叶油醇则在呼吸系统疾病的治疗中表现出良好效果[5],这些特性使其在新药开发及相关疾病的治疗中具有广阔的应用前景。
目前,单萜类化合物的合成主要有3种方法,其中植物提取法产量低、成本高、提取过程复杂,难以满足工业化生产的需求;化学合成法虽在一定程度上可以实现结构可控的合成,但操作过程繁杂、环境不友好,限制了其广泛应用;相比之下,微生物转化法反应条件温和、高效、环保、立体选择性强,已经成为单萜类化合物生产的重要方向[6]。α-蒎烯、β-月桂烯和柠檬烯等萜类化合物是微生物转化的理想起始原料,来源广泛且成本低廉。 尽管这些化合物本身具备抑菌、抗炎、抗氧化和抗癌等多种生物学活性[7],但由于化学性质不稳定且香气值较低,其实际应用仍受到一定限制。而与其具有相同骨架的衍生物,如α-松油醇、香芹醇等,不仅具有独特的芳香气味,是高级香精香料的原料[8-9],而且还具有较高的经济价值和药理作用[10-11]。 近年来,已有多种微生物(包括真菌、细菌和酵母)以α-蒎烯、β-月桂烯和柠檬烯等化合物为前体,通过生物转化法生成高附加值的功能化合物的研究报道[6,9]。 如指状青霉(Penicillium digitatum)能转化柠檬烯生成α-松油醇[12];蓝青霉菌(Absidia corulea)、白腐真菌和黑曲霉(Aspergillus niger)等能转化α-蒎烯生成α-松油醇、马鞭草烯酮、桃金娘烯醇、樟脑、异松香芹醇和马鞭草烯醇[13-15];假单胞菌(Pseudomonas aeruginosa)、红球菌(Rhodococcus erythropolis)和菠萝泛菌(Pantoea ananatis)等能转化β-月桂烯生成芳樟醇、香叶醇和二氢芳樟醇[16-18]。 然而,由于单萜类底物普遍具有高挥发性、低水溶性,且在转化过程中易对微生物产生细胞毒性,导致转化效率偏低[19]。烟草代谢过程中产生的萜类化合物使其内生及附生微生物长期暴露其中,可能逐渐演化出一定的耐受性及生物转化能力[20]。目前,从烟草中筛选萜类化合物转化菌株的研究鲜见报道。
本研究以α-蒎烯、β-月桂烯和柠檬烯为底物,采用唯一碳源法初筛,顶空固相微萃取-气相色谱-质谱(headspace solid-phase microextraction-gas chromatography-mass spectrometry,HS-SPME-GC-MS)复筛,从烟叶中筛选能够生物转化单萜类化合物(α-蒎烯、β-月桂烯和柠檬烯)的菌株,对其进行形态学观察及分子生物学鉴定,并进行生长特性分析以及安全性评估。 以期丰富可用于生物转化的微生物资源库,为转化菌株的生长特性及其安全性评估奠定基础。
1 材料与方法
1.1 材料与试剂
1.1.1 供试材料
烟草样品(昆明CJ34、津巴布韦L10/C):中烟工业有限责任公司。
1.1.2 试剂柠檬烯(纯度为95%)、α-蒎烯(纯度>94%):梯希爱(上海)化成工业发展有限公司;β-月桂烯(纯度≥75%):上海麦克林生化科技股份有限公司;Dzup基因组脱氧核糖核酸(deoxyribonucleic acid,DNA)快速抽提试剂盒、2×Taq Master Mix:生工生物工程(上海)股份有限公司;蛋白胨、酵母浸粉、麦芽提取物(均为生化试剂):北京奥博星生物技术有限责任公司;琼脂(生化试剂)、氯化钠、葡萄糖、环己酮(均为分析纯):天津市大茂化学试剂厂;C7~C30正构烷烃(均为色谱纯):上海阿拉丁生化科技股份有限公司;药敏纸片(12种抗生素):常德比克曼生物科技有限公司。
1.1.3 培养基
5%羊血琼脂培养基:青岛海博生物技术有限公司。
YM液体培养基:葡萄糖10 g/L,蛋白胨5 g/L,酵母浸粉3 g/L,麦芽提取物3 g/L。YM固体培养基:YM液体培养基中添加琼脂20 g/L。121 ℃高压蒸汽灭菌20 min。
M9液体培养基:Na2HPO4 6 g/L,NaCl 0.5 g/L,KH2PO4 3 g/L,NH4Cl 1 g/L,121 ℃高压蒸汽灭菌20 min。灭菌后添加2 mL/L MgSO4(1 mol/L)。
1.2 仪器与设备
HP-5毛细管色谱柱(30 m×320 μm×0.25 μm)、Agilent 6890N-5975B型气相色谱-质谱联用(GC-MS)仪:美国Agilent公司;YX280型手提式不锈钢压力蒸汽灭菌器:上海三申医疗器械有限公司;SW-CJ-1D超净工作台:上海力辰邦西仪器科技有限公司;THZ-98C恒温振荡器:上海一恒科学仪器有限公司;50/30 μm DVB/CAR/PDMS固相微萃取(SPME)萃取头:美国Supeleo公司;DF-101S集热式恒温加热磁力搅拌器:上海力辰邦西仪器科技有限公司;722S可见分光光度计:上海仪电分析仪器有限公司;H2050R大容量高速台式冷冻离心机:湖南湘仪实验室仪器开发有限公司;T100聚合酶链式反应(polymerase chain reaction,PCR)仪:美国Bio-Rad公司。
1.3 方法
1.3.1 单萜类化合物转化菌株的筛选
(1)初筛[21]
取1 g烟草样品于9 mL无菌生理盐水中,30 ℃、150 r/min振荡培养30 min后,得到菌悬液。 取0.5 mL菌悬液接种于装液量为50 mL/250 mL YM液体培养基中,同时加入0.1%(V/V)混合底物(α-蒎烯∶β-月桂烯∶柠檬烯=1∶1∶1,混合底物用已灭菌处理的0.22 μm滤膜过滤除菌),30 ℃、150 r/min振荡培养48 h后,进行10倍浓度梯度稀释至10-7,涂布于YM固体培养基平板中,30 ℃培养48 h,选取不同形状、颜色、大小和形态的单个菌落进行划线培养。 随后,将获得的菌株转接于YM液体培养基中活化培养,取1 mL活化好的菌液接种于装液量为100 mL/250 mL YM液体培养基中,并加入2.0%(V/V)混合底物,重复上述操作,初步筛选能转化α-蒎烯、β-月桂烯或柠檬烯的菌株。
(2)复筛
将初筛菌株转接于YM液体培养基中,30 ℃、150 r/min振荡培养12 h后,离心(5 500×g,15 min)收集菌体,并用0.9%生理盐水洗涤3次,充分去除培养基。之后,考察初筛菌株是否能以混合底物为唯一碳源进行生长转化,将初筛菌株菌体重悬于M9液体培养基中,控制初始OD600 nm值为0.2,并添加1.0%(V/V)混合底物[21],在30 ℃、150 r/min条件下振荡培养88 h,前期每隔2 h测定OD600 nm值,后期每隔4 h或12 h测定OD600 nm值以确定微生物是否生长,复筛能转化α-蒎烯、β-月桂烯或柠檬烯的菌株[19]。
1.3.2 筛选菌株转化产物的检测
将上述筛选菌株接种至YM液体培养基中,30 ℃、150 r/min培养至OD600 nm值=0.8~1.0,因菌株在0.1%(V/V)下转化产物种类最多,所以分别于YM液体培养基中添加0.1%(V/V) 的α-蒎烯、β-月桂烯和柠檬烯进行微生物转化,并于发酵24 h、48 h、72 h时取样,采用顶空固相微萃取-气相色谱-质谱(HS-SPME-GC-MS)法测定转化产物。
HS-SPME条件:取5mL反应后的菌液移入30 mL萃取瓶中,添加100 μL环己酮作为内标(质量浓度为0.946 mg/mL),于磁力搅拌器上40 ℃加热平衡15 min后,插入己活化好的SPME萃取头,推出纤维头,顶空吸附40 min后,插入GC-MS进样口解吸5 min。
GC条件:HP-5毛细管色谱柱(30 m×320 μm×0.25 μm),采用程序升温,起始温度为40 ℃,保持3 min,以3 ℃/min的速率升至160 ℃,保持2 min,再以8 ℃/min的速率升至220 ℃,保持3 min。进样口温度250 ℃,检测器温度250 ℃。
MS条件:电子电离(electron ionization,EI)源,离子源温度230 ℃,四极杆温度150 ℃,电子能量70 eV,全扫描模式,质量扫描范围45~550 amu[22]。
定性定量分析:利用美国国家标准技术研究所(national institute of standards and technology,NIST)质谱数据库进行检索与分析,并根据C7~C30正构烷烃计算化合物保留指数(retention index,RI),与NIST Chemistry WebBook网站中文献保留指数(RI)值进行对比,选择实验测得的RI值与文献报道RI值相差<20的物质。
定量分析:使用环己酮作为内标进行定量分析,香气物质含量计算公式如下:
1.3.3 筛选菌株鉴定
形态学观察:将复筛后的菌株在YM固体培养基上划线培养,观察其菌落颜色、形态等特征,并采用扫描电镜观察其菌体结构。
分子生物学鉴定:使用Dzup基因组DNA快速抽提试剂盒提取样本基因组DNA,以其为模板,采用通用引物27F(5'-AGAGTTTGATCMTGGCTCAG-3')和1492R(5'-GGT TACCTTGTTACGACTT-3')对16S rDNA序列进行聚合酶链式反应(PCR)扩增。PCR扩增体系:2×PCRTaqMix25μL,DNA提取液1 μL,双蒸水(ddH2O)20 μL,引物各2 μL。PCR扩增条件:98 ℃预变性2 min;98 ℃变性10 s,57 ℃退火10 s,72 ℃延伸30 s,共35次循环;72 ℃再延伸5 min。PCR扩增产物送往生工生物工程(上海)有限责任公司测序,测序结果在美国国家生物技术信息中心(national center of biotechnology information,NCBI)GenBank数据库上采用基本局部比对搜索工具(basic local alignment search tool,BLAST)进行比对,得到与待测物种序列相似性最大的同源序列,采用MEGA11.0生物学软件的邻接(neighbor-joining,NJ)法构建系统发育树,确定菌株种属关系。
1.3.4 筛选菌株生长特性分析
(1)生长曲线
将经过鉴定后的菌株按1%(V/V)接种量接种至装液量为100 mL/250 mL YM液体培养基中,在30 ℃、150 r/min的条件下培养60 h,每隔2 h取样,以YM液体培养基为空白对照,测定菌液OD600 nm值,以时间为横坐标、OD600 nm值为纵坐标绘制生长曲线。
(2)不同培养条件对菌株生长的影响
将经过鉴定后的菌株按1%(V/V)接种量接种至装液量为100 mL/250 mL YM液体培养基中,振荡培养24 h,考察不同温度(20 ℃、25 ℃、30 ℃、35 ℃、40 ℃)、转速(100 r/min、150 r/min、200 r/min、250 r/min、300 r/min)、初始pH(3、5、7、9、11)对菌株生长的影响。
1.3.5 菌株安全性
(1)溶血试验
菌株在YM液体培养基中活化之后,蘸取1 μL菌液在5%羊血琼脂培养基上划线,30 ℃培养24 h,观察并记录菌株在培养基上的溶血情况,参照溶血判断标准[23]进行结果分析。
(2)抗生素敏感性实验
采用K-B纸片法进行抗生素敏感性实验,药敏纸片包括:β-内酰胺类药物(青霉素、阿莫西林、头孢呲肟);氨基糖苷类药物(庆大霉素、链霉素、卡那霉素);喹诺酮类药物(诺氟沙星、环丙沙星);糖肽类药物(万古霉素);林可酰胺类药物(林可霉素);链阳菌素类药物(红霉素);其他类药物(利福平)。
菌株在YM液体培养基中活化之后,取100 μL菌液均匀涂布于YM固体培养基上,用无菌镊子夹取药敏纸片贴在培养基表面,30 ℃培养24 h,测量抑菌圈直径,根据《抗微生物药物敏感性试验执行标准》以及杜丽娜等[24]的药敏试验方法判断菌株的药物敏感性。
1.3.6 数据处理
采用Excel 2021、GraphPad Prism 9.5.0和Origin 2019进行数据处理和绘图。 采用SPSS 24.0进行单因素方差分析,采用邓肯法进行显著性分析。
2 结果与分析
2.1 单萜类化合物转化菌株的筛选
2.1.1 初筛
在昆明CJ34和津巴布韦L10/C烟草样品中分别添加0.1%(V/V)混合底物,经YM液体培养基活化培养和梯度稀释涂布分离后涂布于YM固体培养基平板中,30 ℃培养48 h,挑取菌落分离明显、长势良好的单菌落,共获得50株。在此基础上,筛选能在添加2.0%(V/V)混合底物YM液体培养基生长菌株6株。
2.1.2 复筛
将6株初筛菌株的菌体重悬于添加1.0%(V/V)混合底物的M9液体培养基中,在30 ℃、150 r/min条件下振荡培养88 h,以混合底物作为唯一碳源进行生长的菌株有2株,分别编号为CJ14和L-2。
2.2 筛选菌株转化产物的检测
将菌株CJ14和L-2均接种至分别添加0.1%(V/V)α-蒎烯、β-月桂烯及柠檬烯的YM液体培养基中进行微生物转化,并于发酵24 h、48 h、72 h时取样,采用HS-SPME-GC-MS法检测菌株CJ14和L-2转化产物,结果见表1。 由表1可知,菌株CJ14转化α-蒎烯的产物包括(-)-反式-松香芹醇、松香芹酮、α-松油醇、柠檬烯和β-月桂烯;转化β-月桂烯的产物包括α-松油醇、异佛尔酮、桉叶油醇、二氢香芹醇;转化柠檬烯的产物包括二氢香芹醇和4-萜烯醇。α-蒎烯的转化产物中,(-)-反式-松香芹醇和α-松油醇的含量在24 h分别为28.20 mg/L和9.35 mg/L;松香芹酮、柠檬烯和β-月桂烯的含量在48 h分别为10.44 mg/L、2.06 mg/L和2.41 mg/L。β-月桂烯的转化产物均在24 h时含量较高,随后随着转化时间的延长逐渐减少,甚至未检出。 柠檬烯的转化产物主要为二氢香芹醇,其含量在24 h为24.93 mg/L;4-萜烯醇仅在发酵72 h时被检出。
表1 不同底物条件下菌株CJ14与L-2发酵过程中转化产物的差异
Table 1 Difference of products transformed by strains CJ14 and L-2 during fermentation under different substrate conditions

注:“-”表示数据库中无该化合物RI值或未检出该化合物。 文献RI值来源于NIST Chemistry WebBook网站数据库(https://webbook.nist.gov)。
含量/(mg·L-1)底物 产物 RI值 文献RI值24 h菌株CJ14 48 h 24 h 72 h菌株L-2 48 h 72 h YM液体培养基+0.1%(V/V)α-蒎烯α-松油醇松香芹酮(-)-反式-松香芹醇柠檬烯β-月桂烯1 199 1 159 1 139 1 028 992 1 195 1 164 1 139-992 9.35±1.40 5.50±0.74 28.20±4.32---10.44±3.73 5.82±2.64 2.06±2.22 2.41±1.94-- - - ---6.20±1.48 30.18±4.17 7.85±0.84-0.53±1.50 8.73±0.50-9.07±2.85-2.28±0.40 3.64±1.45 0.81±0.57-0.75±0.13---YM液体培养基+0.1%(V/V)β-月桂烯-- -5.82±0.45 80.17±12.70 4.45±0.15 YM液体培养基+0.1%(V/V)柠檬烯α-松油醇齿小蠹二烯醇异佛尔酮桉叶油醇二氢香芹醇4-萜烯醇二氢香芹醇1 199 1 151 1 128 1 030 1 218 1 177 1 218 1 195 1 150 1 127 1 030 1 200 1 177 1 200 2.06±0.30-1.11±0.79 1.30±0.35 1.47±0.24-24.93±3.39 1.39±0.65-0.26±0.39 0.43±0.35 1.40±0.52-22.15±0.35-- - --- - --- - -1.17±0.16 2.51±0.09 19.60±1.25 27.49±1.59 27.12±3.48 20.16±0.52
菌株L-2转化α-蒎烯的产物包括柠檬烯、β-月桂烯、(-)-反式-松香芹醇和松香芹酮;转化β-月桂烯的产物为齿小蠹二烯醇;转化柠檬烯的产物为二氢香芹醇。 在α-蒎烯的转化过程中,柠檬烯的含量在24 h为30.18 mg/L,在48 h和72 h含量相对较少甚至未检出;β-月桂烯和(-)-反式-松香芹醇的含量在48 h分别为9.07 mg/L和8.73 mg/L,松香芹酮的含量在72 h为2.28 mg/L。 对于β-月桂烯的转化产物齿小蠹二烯醇,其含量在48 h为80.17 mg/L,明显高于24 h(5.82 mg/L)和72 h(4.45 mg/L)。对于柠檬烯的转化产物二氢香芹醇,其含量在24 h为27.49 mg/L,随后随着转化时间的延长含量逐渐减少。
综上,菌株CJ14和L-2具有转化单萜类化合物的能力,能将α-蒎烯、β-月桂烯和柠檬烯转化生成松香芹醇、松香芹酮、α-松油醇、齿小蠹二烯醇和二氢香芹醇等高附加值化合物。
2.3 筛选菌株的鉴定
2.3.1 形态学观察
菌株CJ14和L-2菌落(A)及菌体(B、C)形态见图1。 由图1A可知,菌株CJ14在YM培养基培养48 h后,菌落呈圆形乳黄色、不透明、边缘规则、中心凸起、表面光滑湿润。菌株L-2的菌落呈不规则圆形,边缘呈叶状扩散,表面可见褶皱状。 由图1B、1C可知,菌株CJ14菌体呈杆状、卵圆形[25],菌株L-2菌体呈杆状[26]。

图1 菌株CJ14和L-2菌落(A)及菌体(B、C)形态
Fig.1 Morphology of colonies (A) and cells (B, C) of strains CJ14 and L-2
2.3.2 菌株分子生物学鉴定结果
基于16S rDNA序列菌株CJ14和L-2系统发育树见图2。

图2 基于16S rDNA基因序列菌株CJ14(A)和L-2(B)的系统发育树
Fig.2 Phylogenetic trees of strains CJ14 (A) and L-2 (B)based on 16S rDNA gene sequences
由图2A可知,菌株CJ14与伯克霍尔德菌(Burkholderia sp.)TNe-862聚类在同一分支,相似度为100%。由图2B可知,菌株L-2与暹罗芽胞杆菌(Bacillussiamensis)KCTC 13613、枯草芽孢杆菌(Bacillus subtilis)IAM 12118、Bacillus cabrialesii TE3聚类在同一分支,相似度为99%。因此,由形态学观察及分子生物学方法鉴定菌株CJ14为伯克霍尔德菌(Burkholderia sp.),命名为伯克霍尔德菌CJ14;菌株L-2为芽孢杆菌(Bacillus sp.),命名为芽孢杆菌L-2。
2.4 菌株生长特性分析
2.4.1 菌株生长曲线测定
菌株CJ14和L-2的生长曲线见图3。由图3可知,在30 ℃、150 r/min的条件下,伯克霍尔德菌CJ14在0~4 h处于迟缓期;6~48 h生长迅速,处于对数生长期;48~52 h,菌株处于稳定期;52 h之后,进入衰亡期。芽孢杆菌L-2在0~6 h处于迟缓期;6~16 h生长迅速,处于对数生长期;16~38 h处于稳定期;38 h后进入衰亡期。

图3 菌株CJ14和L-2的生长曲线
Fig.3 Growth curves of strains CJ14 and L-2
2.4.2 不同培养条件对菌株生长的影响
温度、转速及pH值对菌株OD600 nm值的影响见图4。 由图4A可知,随着温度在20~30 ℃范围内的增加,菌株CJ14、L-2的OD600nm值均增加;当温度为30 ℃时,OD600 nm值均最高(CJ14达到3.886,L-2达到3.804);当温度>30 ℃时,菌株OD600 nm值呈下降趋势,生长受到抑制,而菌株L-2在35~40 ℃时又出现轻微回升现象,这可能是因为菌株启动了高温适应机制[27-28],但仍未达到30 ℃的水平。因此,2株菌的最适生长温度均为30 ℃。

图4 温度(A)、转速(B)及初始pH值(C)对菌株CJ14和L-2 OD600 nm值的影响
Fig.4 Effects of temperature (A), rotational speed (B) and pH (C) on the OD600 nm value of strains CJ14 and L-2
不同小写字母表示差异显著(P<0.05)。
由图4B可知,随着转速在100~300 r/min范围内的增加,菌株CJ14的OD600 nm值增加;当转速达到300 r/min时,其发酵液的OD600 nm值达到7.992,其原因可能是,转速的提高有助于增强氧传递速率及营养物质的扩散,从而有利于需氧型伯克霍尔德菌的生长[29]。 当转速低于150 r/min时,菌株L-2 OD600 nm值较低;转速为150 r/min时,OD600 nm值最高,为3.744;当转速为150~200 r/min,OD600 nm值有所下降;当转速>200 r/min,OD600 nm值趋于稳定。 杨冬静等[30]研究表明,解淀粉芽孢杆菌(Bacillus amyloliquefaciens)XZ-1的最适转速为150 r/min,转速过高或过低均会抑制菌株的生长。因此,菌株CJ14和L-2的最适生长转速分别为300 r/min和150 r/min。
由图4C可知,当pH值为3~9时,菌株CJ14的OD600 nm值先快速增加后缓慢增加;当pH值为9时,OD600 nm值达到峰值,为3.80;当pH值为9~11时,OD600nm值开始下降。当pH值为3~5时,菌株L-2的OD600 nm值快速增加;当pH值为5时,OD600 nm值最高,为4.15;当pH值为5~11时,OD600 nm值迅速下降。 低pH环境会导致膜脂质极性头部质子化,膜流动性骤降,形成渗漏孔道,造成胞内离子外泄,细胞结构完整性受损[31]。 高pH环境会水解磷脂分子的酯键,破坏双分子层结构,导致细胞膜崩解,最终细胞死亡[32]。 综上,菌株CJ14和L-2的最适生长pH分别为9和5。
2.5 菌株安全性
溶血性实验是一种用于检测菌株是否产生溶血素(即具有破坏红细胞膜并导致溶血能力的毒素)的实验方法,是评估菌株安全性的重要依据之一[33]。菌株CJ14和L-2的溶血实验结果见图5。由图5可知,菌株CJ14和L-2在5%羊血琼脂培养上未引起溶血现象,培养基外观无明显变化,表现为γ-溶血现象,表明该菌株具有良好的安全性。
图5 菌株CJ14(A)和L-2(B)的溶血实验结果
Fig.5 Hemolysis tests results of strains CJ14 (A) and L-2 (B)
抗生素敏感性实验也是评估菌株安全性的重要依据之一,菌株CJ14和L-2的抗生素敏感性实验结果见表2。 由表2可知,菌株L-2对青霉素、阿莫西林、头孢呲肟、链霉素、卡那霉素、诺氟沙星、环丙沙星、万古霉素、红霉素、利福平敏感;对庆大霉素中度敏感;对林可霉素耐药。而菌株CJ14对上述所有抗生素均耐药。
表2 菌株CJ14(A)和L-2(B)的抗生素敏感性实验结果
Table 2 Antibiotic sensitivity tests results of strains CJ14 (A) and L-2 (B)

注:S,敏感;I,中度敏感;R,耐药。
抗生素 伯克霍尔德菌CJ14抑菌圈直径/mm 敏感性芽孢杆菌L-2抑菌圈直径/mm 敏感性青霉素阿莫西林头孢呲肟庆大霉素链霉素卡那霉素诺氟沙星环丙沙星万古霉素林可霉素红霉素利福平77788876 7881 6 RRRRRRRRRRRR 30 32 32 13 16 18 26 30 21 0 25 21 SSSISSSSSRSS
综上,伯克霍尔德菌CJ14对抗生素具有耐药性,无溶血活性,该结果与多数相关研究的报道一致[34-35]。相比之下,芽孢杆菌L-2对大多数抗生素表现出敏感性,同时也不具有溶血活性,显示出较高的安全性,这为其在食品工业和发酵生产中的潜在应用提供了科学依据和理论基础。先前的研究也报道多株芽孢杆菌对万古霉素、庆大霉素、四环素、红霉素和克林霉素等抗生素敏感,且均未表现出溶血现象[36],进一步表明其具备良好的安全性。
3 讨论
伯克霍尔德菌是一类革兰氏阴性、需氧的条件致病菌,具有降解碳氢化合物和卤代溶剂等环境污染物的能力,可生产脂肪酶、蛋白酶等工业用酶,并能合成生物塑料前体,在环境生物修复、食品加工与医药开发等领域备受关注[37-38]。 本研究从烟草样本中分离并鉴定出一株伯克霍尔德菌CJ14,该菌株虽然对抗生素耐药,无溶血活性,但对α-蒎烯、β-月桂烯和柠檬烯等单萜类化合物表现出一定的生物转化能力。 其中,菌株CJ14生物转化α-蒎烯的主要产物为(-)-反式-松香芹醇、松香芹酮和α-松油醇。松香芹醇和松香芹酮具有清凉木质样的香气特征以及驱虫、抗菌、防霉等生物活性;α-松油醇具有稳定的紫丁香香气以及抗氧化、消炎止痛、抗癌、神经保护、抗痉挛等药理学活性,已被广泛地应用于医药、食品、农业、化妆品等行业[39]。值得注意的是,目前尚未见关于伯克霍尔德菌生物转化α-蒎烯的相关报道。菌株CJ14对β-月桂烯的生物转化产物包括α-松油醇、异佛尔酮、桉叶油醇和二氢香芹醇,但各产物的产量均较低。 菌株CJ14对柠檬烯生物转化主要产物为二氢香芹醇。二氢香芹醇是一种具有留兰香和胡椒样香气的环氧单萜类化合物,与香芹酮、香芹醇及二氢香芹酮同属香芹类化合物。二氢香芹醇不仅是多种药物和精细化学品的重要中间体,还具有驱虫、杀螨和抑菌等多种生物活性,可作为熏蒸剂和驱避剂应用于粮油储藏[4]。 尽管已有研究报道柠檬烯可通过生物转化生成香芹类化合物,但以柠檬烯为底物直接转化生成二氢香芹醇的研究却较少,通常是以香芹酮或二氢香芹酮为起始底物[6]。
芽孢杆菌是一类能够形成芽孢的革兰氏阳性细菌,具有良好的耐受性和多种生物活性,不仅可以降解有机污染物和重金属,还可以在温和条件下将天然产物或药物前体转化为高附加值的功能化合物。已有研究表明,芽孢杆菌可将α-蒎烯转化为α-蒎烯氧化物、马鞭草烯醇和桃金娘烯醇[40];将柠檬烯转化为紫苏醇、α-松油醇、香芹醇和柠檬烯环氧化物[6]。 本研究从烟草样本中筛选得到的芽孢杆菌L-2不仅具有较高的生物安全性,而且对α-蒎烯、β-月桂烯、柠檬烯表现出较好的转化能力,具有潜在的工业应用前景。菌株L-2生物转化α-蒎烯的产物包括柠檬烯、β-月桂烯、(-)-反式-松香芹醇和松香芹酮。值得注意的是,菌株L-2对β-月桂烯的生物转化产物为齿小蠹二烯醇。尽管已有研究报道以β-月桂烯为底物合成齿小蠹二烯醇,但多采用化学合成方法,存在能耗高、环境污染大等问题[41]。本研究采用安全性较高的芽孢杆菌L-2,通过微生物转化法高效、专一地合成齿小蠹二烯醇,反应条件温和、环境友好、产物专一性强,是一种具有应用前景的绿色合成路径。此外,与伯克霍尔德菌CJ14类似,菌株L-2生物转化柠檬烯的产物也是二氢香芹醇。
4 结论
本研究采用唯一碳源法初筛,顶空固相微萃取-气相色谱质谱(HS-SPME-GC-MS)复筛,从烟草样品中分离获得2株能够利用混合底物作为唯一碳源生长的菌株(编号分别为CJ14、L-2)。这两株菌不仅对α-蒎烯、β-月桂烯、柠檬烯等单萜类化合物具有良好的耐受能力,还能将其生物转化为松香芹醇、松香芹酮、α-松油醇、齿小蠹二烯醇和二氢香芹醇等化合物,经形态学观察和分子生物学鉴定,菌株CJ14和L-2分别被鉴定为伯克霍尔德菌和芽孢杆菌。其最适生长温度均为30 ℃,最适生长转速分别为300 r/min和150 r/min,最适生长pH分别为9和5。 菌株CJ14和L-2无溶血现象,其中,菌株L-2对11种抗生素敏感,表现出较高的安全性。 综上,菌株L-2具有优良的生长性能及安全性,可作为单萜类化合物转化菌株,提高单萜类化合物的附加值。 未来可进一步优化其生物转化工艺,以实现规模化生产;同时,挖掘与目标产物合成相关的功能基因或酶,并通过定向进化等手段提升其催化活性,从而提高转化效率与产物产量。
[1]高琪,肖文海.酵母合成单萜类化合物的研究进展[J].合成生物学,2025,6(2):357-372.
[2]张大江,王培荣,毛治超,等.香精油和原油中单萜类单体化合物稳定碳同位素组成[J].中国科学:地球科学,2010,40(3):319-326.
[3]AN Q, REN J N, LI X, et al.Recent updates on bioactive properties of linalool[J].Food Funct,2021,12(21):10370-10389.
[4]ZHANG L L,CHEN Y,LI Z J,et al.Bioactive properties of the aromatic molecules of spearmint(Mentha spicata L.) essential oil: a review[J].Food Funct,2022,13(6):3110-3132.
[5]JUERGENS U R,DETHLEFSEN U,STEINKAMP G,et al.Anti-inflammatory activity of 1.8-cineol (eucalyptol) in bronchial asthma: a doubleblind placebo-controlled trial[J].Resp Med,2003,97(3):250-256.
[6]ZHANG L L, WANG W Y, WANG Z X, et al.Biotransformation of limonene:pathways,biocatalysts,and applications[J].Food Biosci,2025,69:106812.
[7]杨尚桦,张猛猛,辛璇,等.柑橘类果实精油的化学成分、生物活性及其安全性的研究进展[J/OL].现代食品科技,1-15[2025-12-07].https://doi.org/10.13982/j.mfst.1673-9078.2026.2.1708.
[8]BEHR A,JOHNEN L.Myrcene as a natural base chemical in sustainable chemistry:a critical review[J].Chem Sus Chem,2009,2(12):1072-1095.
[9]NDAO A,ADJALLÉ K.Overview of the biotransformation of limonene and α-pinene from wood and citrus residues by microorganisms[J].Waste,2023,1(4):841-859.
[10]MOLINA G,PESSOA M G,BICAS J L,et al.Optimization of limonene biotransformation for the production of bulk amounts of α-terpineol[J].Bioresource Technol,2019,294:122180.
[11]DE OLIVEIRA FELIPE L,DE OLIVEIRA A M,BICAS J L.Bioaromas-Perspectives for sustainable development[J].Trends Food Sci Tech,2017,62:141-153.
[12]黄佳琳,张婷,王子轩,等.转录因子PdTP1在指状青霉中调控α-松油醇合成及菌株生长的分子机制[J/OL].现代食品科技,1-13[2025-12-07].https://doi.org/10.13982/j.mfst.1673-9078.2026.3.0031.
[13]SIDDHARDHA B, KUMAR M V, MURTY U S N, et al.Biotransformation of α-pinene to terpineol by resting cell suspension of Absidia corulea[J].Indian J Microbiol,2012,52(2):292-294.
[14]LEE S Y,KIM S H,HONG C Y,et al.Biotransformation of(-)-α-pinene by whole cells of White Rot Fungi,Ceriporia sp.ZLY-2010 and Stereum hirsutum[J].Mycobiology,2015,43(3):297-302.
[15]VIDYA C M,AGRAWAL R.Production of verbenol,a high valued food flavourant from a fusant strain of Aspergillus niger[J].Appl Microbiol Biotechnol,2003,62(4):421-422.
[16]张逸凡,付冬梅,薛兆茹,等.酒花内生菌转化β-月桂烯合成芳樟醇和香叶醇[J].食品研究与开发,2023,44(1):167-173.
[17]THOMPSON M L,MARRIOTT R,DOWLE A,et al.Biotransformation of β-myrcene to geraniol by a strain of Rhodococcus erythropolis isolated by selective enrichment from hop plants[J].Appl Microbiol Biot,2010,85(3):721-730.
[18]ESMAEILI A, HASHEMI E.Biotransformation of myrcene by Pseudomonas aeruginosa[J].Chem Cent J,2011,5:26.
[19]CHEN L,ZHANG L L,REN J N,et al.Screening a strain of Klebsiella sp.O852 and the optimization of fermentation conditions for trans-dihydrocarvone production[J].Molecules,2021,26(9):2432.
[20]蒋彪,侯佩,罗朝鹏,等.烟草合成生物学研究进展[J].中国生物工程杂志,2025,45(6):128-138.
[21]BICAS J L,PASTORE G M.Isolation and screening of D-limonene-resistant microorganisms[J].Braz J Microbiol,2007,38(3):563-567.
[22]LI Z H,WANG Z X,ZHANG L L,et al.A strategy of extracting and purifying the α-terpineol obtained from the Penicillium digitatum biotransformation of limonene[J].Prep Biochem Biotech, 2025, 55(9): 1191-1199.
[23]陈希,索占伟,许剑琴,等.细菌溶血素的分类及代表性溶血素研究进展[J].中国农学通报,2008(8):16-22.
[24]杜丽娜,檀冰凝,任桐瑶,等.枯草芽孢杆菌XE-2的分离鉴定及生物学特性分析[J].唐山师范学院学报,2024,46(6):47-50,73.
[25]吕俊,于存.一株高效溶磷伯克霍尔德菌的筛选鉴定及对马尾松幼苗的促生作用[J].应用生态学报,2020,31(9):2923-2934.
[26]戴淑珍,杨子宜,钟秀斌,等.产γ-聚谷氨酸菌株Bacillus siamensis LBY-7的筛选、发酵条件优化及抑菌活性初步研究[J].应用海洋学学报,2025,44(2):302-311.
[27]MUMCU H,CEBECI E T S,KILIC M M,et al.Identification of phenotypic and genotypic properties and cold adaptive mechanisms of novel freeze-thaw stress-resistant strain Pseudomonas mandelii from Antarctica[J].Polar Biol,2023,46:169-183.
[28]宋晓华,尹镜雲,王晨宇,等.温泉嗜热蓝藻高温适应机制的研究进展[J].微生物学通报,2025,52(8):3440-3457.
[29]WAGLEY S, HEMSLEY C, THOMAS R, et al.The twin arginine translocation system is essential for aerobic growth and full virulence of Burkholderia thailandensis[J].J Bacteriol,2014,196(2):407-416.
[30]杨冬静,赵永强,孙厚俊,等.解淀粉芽孢杆菌(Bacillus amyloliquefaciens)XZ-1发酵条件的优化[J].江西农业学报,2017,29(10):35-39.
[31]XU J N,ZHAO N,MENG X M,et al.Transcriptomic and metabolomic profiling uncovers response mechanisms of Alicyclobacillus acidoterrestris DSM 3922T to acid stress[J].Microbiol Spectr,2023,11(4):e0002223.
[32]DUCHÉ G, SANDERSON J M.The chemical reactivity of membrane lipids[J].Chem Rev,2024,124(6):3284-3330.
[33]张鑫宇,赖泽萍,石鸿辉,等.稻米内生贝莱斯芽孢杆菌BR-1的安全性评估[J].食品与生物技术学报,2025,44(2):112-121.
[34]SETHI S, SHARMA M, KUMAR S, et al.Antimicrobial susceptibility pattern of Burkholderia cepacia complex&Stenotrophomonas maltophilia from North India:trend over a decade(2007-2016)[J].Indian J Med Res,2020,152(6):656-661.
[35]SCHWEIZER H P.Mechanisms of antibiotic resistance in Burkholderia pseudomallei:implications for treatment of melioidosis[J].Future Microbiol,2012,7(12):1389-1399.
[36]ADIMPONG D B,SØRENSEN K I,THORSEN L,et al.Antimicrobial susceptibility of Bacillus strains isolated from primary starters for African traditional bread production and characterization of the bacitracin operon and bacitracin biosynthesis[J].Appl Environ Microbiol,2012,78(22):7903-7914.
[37]MAHANTA N,GUPTA A,KHARE S K.Production of protease and lipase by solvent tolerant Pseudomonas aeruginosa PseA in solid-state fermentation using Jatropha curcas seed cake as substrate[J].Bioresource Technol,2008,99(6):1729-1735.
[38]SILVA-SANTANA G,SALES F L S,AGUIAR A R,et al.Pharmaceutical contamination by biofilms formed of the Burkholderia cepacia complex:public health risks[J].Processes,2025,13(5):1270.
[39]CHEN Y,ZHANG L L,WANG W Y,et al.Recent updates on bioactive properties of α-terpineol[J].J Essent Oil Res,2023,35(3):274-288.
[40]SCHEWE H, HOLTMANN D, SCHRADER J.P450(BM-3)-catalyzed whole-cell biotransformation of α-pinene with recombinant Escherichia coli in an aqueous-organic two-phase system[J].Appl Microbiol Biotechnol,2009,83(5):849-857.
[41]MARCO-CONTELLES J.The synthesis of ipsenol and ipsdienol:a review(1968-2020)[J].Chem Rec,2021,21(4):858-878.